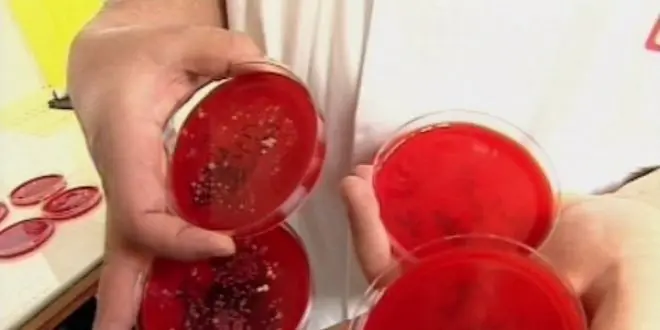

Découverte d'un processus antibiotique inédit et prometteur
En réunissant les conclusions de leurs récentes découvertes sur la structure des bactéries, des chercheurs de l'Institut Karolinska viennent de mettre au point un nouveau type d'antibiotique. Ciblant le niveau le plus fondamental des cellules, ce procédé ouvre des très sérieuses perspectives pour le traitement de la tuberculose, le staphylocoque aureus résistant (SARM) ou les ulcères de l'estomac.
Mis à jour le
Les thioredoxines sont des protéines présentes dans la plupart des cellules vivantes, des bactéries aux mammifères. Pour cause : celles-ci sont indispensables à la formation de nouveaux brins d'ADN, ainsi qu'à la protection des cellules contre l'oxydation.
L'activité de ces protéines est régulée par une enzyme spécifique dont la structure, chez les bactéries, diffère singulièrement de celle identifiée dans les organismes plus complexes. L'équipe suédoise du professeur Arne Holmgren, qui avait identifié ces différences, a récemment ajouté une découverte à son palmarès.
Des bactéries manquant de ressources
Elle a en effet observé qu'une molécule, dénommée ebsélène, empêchait le fonctionnement de cette enzyme dans de nombreuses bactéries. Spécificité de ces souches : l'absence d'un système similaire à celui qui met en jeu les thiorédoxines, qui leur supplée en cas de défaillance.
"Notre équipe a donc pu imaginer utiliser l'ebsélène a des fins antibiotiques," nous relate le professeur Arne Holmgren. "Certaines molécules parviennent déjà à interrompre la synthèse de l'ADN. Le mécanisme imaginé par notre équipe cible le mécanisme central de cette synthèse."
Le chercheur détaille avec passion le processus mis en jeu. "Chaque cycle d'assemblage de l'ADN est commandé par un cycle du système thioredoxyne. Bloquer ce dernier interrompt immédiatement le développement de la cellule ciblée."
La découverte est loin d'être anecdotique. Parmi les bactéries pour lesquelles aucune alternative n'existe au système thioredoxine, on trouve en effet des maladies graves pour lesquelles peu de traitements existent encore.
"Aujourd'hui, nous souhaitons démarrer les essais cliniques pour des infections spécifiques, telles que celles liées aux staphylocoque aureus résistant (SARM), dont certaines souches résistent encore à toutes les stratégies antibiotiques. D'autres maladies inflammatoires pourraient également être ciblées. Le mécanisme que nous avons mis au jour pourrait enfin être utilisé dans de nombreux cas où les antibiotiques à large spectre sont inefficaces."
Source : "Inhibition of bacterial thioredoxin reductase: an antibiotic mechanism targeting bacteria lacking glutathione", The FASEB Journal, December 17, 2012, doi: 10.1096/fj.12-223305
En savoir plus
Sur Allodocteurs.fr :
Les antibiotiques sont des molécules qui détruisent ou bloquent la croissance des bactéries. Leurs modes d'actions sont variés.
La célèbre pénicilline empêche ainsi la synthèse de la paroi de ces bactéries. D'autres types fragilisent la membrane plasmique dont l'intégrité est indispensable à la survie bactérienne.
Le processus peut également consister à inhiber la synthèse de différents constituants essentiels des cellules (lipides, acides aminés, nucléotides, protéines).
Un dernier mode d'action consiste à empêcher la production des acides nucléiques.
La découverte du professeur Holmgren rentre dans cette dernière catégorie.










